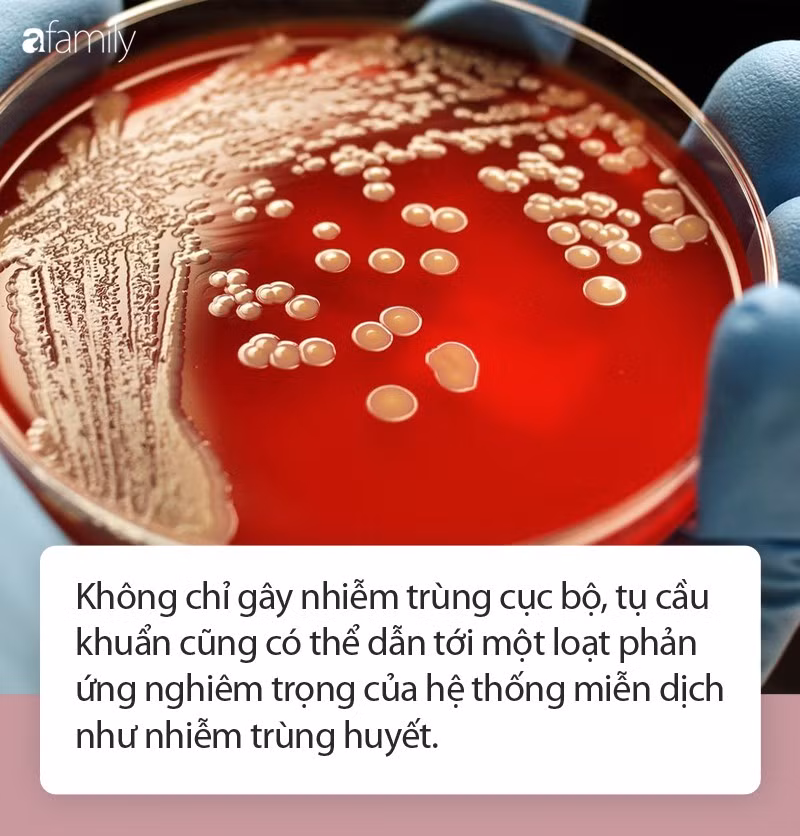
t1

Theo Thư viện Y khoa Quốc gia Hoa Kỳ, tụ cầu khuẩn (Staphylococcus) là một nhóm vi khuẩn bao gồm hơn 30 loại khác nhau. Paul Fey, tiến sĩ, trưởng khoa vi trùng học tại Trung tâm Y tế trực thuộc Đại học Nebraska cho biết, hầu hết những vi sinh vật này đều thân thiện, sống trên cơ thể chúng ta không gây ra vấn đề gì.
Bạn có thể tìm thấy tụ cầu khuẩn trong mũi, trên da và thậm chí ở các màng nhầy ở khu vực hậu môn.
Tuy vậy, một số loại tụ cầu khuẩn có khả năng gây nhiễm trùng và bệnh tật khi nằm ở những nơi vốn không thuộc về chúng. Theo Joshua Zeichner, bác sĩ kiêm chuyên gia da liễu tại Bệnh viện Mount Sinai, thành phố New York cho biết, nhiễm trùng tụ cầu khuẩn thường khởi nguồn từ những vết trầy xước trên da, vết rách do cạo râu hoặc thậm chí nấm chân. Không chỉ gây nhiễm trùng cục bộ, tụ cầu khuẩn cũng có thể dẫn tới một loạt phản ứng nghiêm trọng của hệ thống miễn dịch như nhiễm trùng huyết.
Gary Goldenberg, chuyên gia y khoa, phó giáo sư về da liễu tại Trường YIcahn trực thuộc Bệnh viện Mount Sinai giải thích, người bệnh hoàn toàn có thể tử vong nếu tụ cầu khuẩn xâm nhập vào máu hoặc lây nhiễm tới các cơ quan nội tạng.
Dưới đây là những dấu hiệu nhận biết vấn đề sức khỏe này và lời khuyên của các chuyên gia:
Xuất hiện mụn nhọt chảy mủ
Thâm da do bị viêm hoặc chảy mủ là dấu hiệu nhiễm trùng tụ cầu khuẩn cơ bản nhất. Chuyên gia Fey giải thích: "Các tụ cầu khuẩn sẽ theo móng tay tới nhiều khu vực trên cơ thể khi bạn gãi do muỗi đốt. Nếu vô tình chạm vào vết trầy xước trên da, chúng sẽ lây nhiễm và khiến vết thương này trở nên nghiêm trọng hơn, gây sưng đỏ, đau và hình thành mủ".
Bạn cũng có thể nhận thấy nhiều mụn nước xuất hiện giống phát ban.
Trên thực tế, rất nhiều người nhầm lẫn giữa nhiễm trùng tụ cầu khuẩn với vết cắn do côn trùng hay động vật gây ra.
Nhiễm trùng da
Tụ cầu khuẩn là nguyên nhân phổ biến nhất gây viêm mô tế bào, một bệnh nhiễm trùng da nghiêm trọng do vi khuẩn gây nên. Tình trạng này hoàn toàn có thể xảy ra ở những người khỏe mạnh và sở hữu hệ thống miễn dịch yếu.
Chuyên gia Goldenberg giải thích, tụ cầu khuẩn thường xâm nhập vào da thông qua vết cắt và gây nhiễm trùng cục bộ, kéo theo viêm da. Các triệu chứng phổ biến nhất bao gồm sưng đau, xuất hiện mảng da đỏ nhạy cảm thường ở dưới chân, mặt hoặc cánh tay.
Nếu bạn gặp phải bất kỳ vấn đề về da gây đau đớn hoặc khó chịu, hãy đến bác sĩ càng sớm càng tốt. Viêm mô tế bào có thể tiến triển nhanh chóng nếu không điều trị kịp thời.
Ngộ độc thực phẩm
Khi thực phẩm tiếp xúc với tụ cầu khuẩn, các vi khuẩn sẽ sinh sôi và tạo ra độc tố. Theo Trung tâm kiểm soát và phòng ngừa dịch bệnh Hoa Kỳ (CDC), các loại độc tố này có thể gây bệnh, dẫn đến những triệu chứng như nôn mửa, tiêu chảy và đau dạ dày trong vòng 30 phút đến 8 giờ sau khi bạn tiêu thụ ăn thực phẩm nhiễm độc.

Khi thực phẩm tiếp xúc với tụ cầu khuẩn, các vi khuẩn sẽ sinh sôi và tạo ra độc tố.
Các cách tốt nhất để tránh ngộ độc thực phẩm liên quan đến tụ cầu khuẩn là đảm bảo quá trình chế biến thức ăn sạch sẽ. Thực phẩm nên được nấu ở nhiệt độ ít nhất 60°C và bảo quản lạnh dưới 4,5°C. Ngoài ra, mọi người cần lưu ý rửa tay ít nhất 20 giây với xà phòng trước khi nấu hoặc tiêu thụ thức ăn.
Sốt và huyết áp thấp
Trong một số trường hợp, tụ cầu khuẩn có thể xâm nhập vào máu khi bạn tiếp xúc với chúng tại môi trường đặc biệt như bệnh viện, phẫu thuật. Vi khuẩn này có khả năng gây nhiễm trùng máu còn được gọi là nhiễm khuẩn huyết. Các triệu chứng ban đầu bao gồm sốt và huyết áp thấp.
Khi đã vào máu, tụ cầu khuẩn có thể lan đến tim, xương và các cơ quan nội tạng, dẫn đến một số bệnh nhiễm trùng nghiêm trọng hoặc thậm chí gây tử vong.
Hội chứng sốc nhiễm độc cấp tính
Các tụ cầu khuẩn tích tụ có thể gây ra một dạng ngộ độc máu đặc biệt mang tên hội chứng sốc nhiễm độc cấp tính (TSS). Nếu bạn nhận thấy những triệu chứng bất thường như sốt đột ngột, nôn mửa, tiêu chảy, đau cơ, nhức đầu và phát ban ở lòng bàn tay và chân, đừng ngại ngần đi khám càng sớm càng tốt.
Trên thực tế, theo dữ liệu từ CDC, tình trạng này khá hiếm và trong 100000 người thì chỉ có một người mắc.

Các tụ cầu khuẩn tích tụ có thể gây ra một dạng ngộ độc máu đặc biệt mang tên hội chứng sốc nhiễm độc cấp tính (TSS).
Nhiễm trùng huyết
Nếu nhiễm trùng tụ cầu khuẩn không được điều trị, chúng có thể xâm nhập vào máu và dẫn đến nhiễm trùng huyết. Chuyên gia Goldenberg cho biết, tình trạng này bắt nguồn từ phản ứng mạnh mẽ của hệ thống miễn dịch trước hóa chất gây hại trong máu và các cơ quan nội tạng.
Nhiễm trùng máu hoàn toàn có khả năng ngăn chặn quá trình lưu thông máu và khiến cơ thể bạn ngừng hoạt động từ đó gây tử vong. Các triệu chứng chủ yếu bao gồm tăng nhịp tim, sốt, run rẩy và cảm thấy lạnh, khó thở, cực kỳ đau đớn, sạm da hoặc đổ mồ hôi.





































